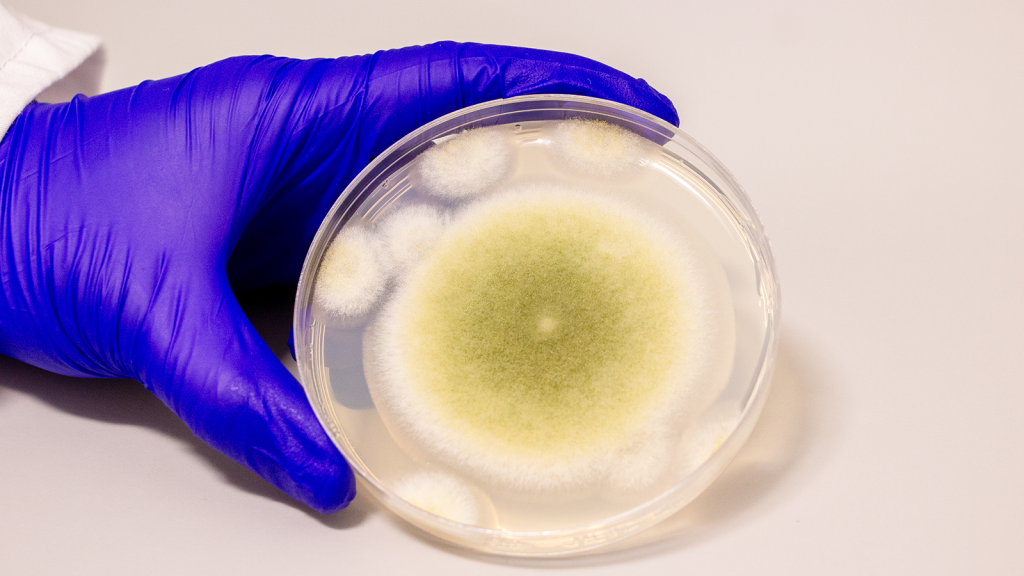
Tomb 'curse' of ancient mummy leads to new cancer treatment medication

Former camp counselor warned of wanting to initiate a violent attack if kids upset him

A former counselor at a Christian camp in Texas allegedly threatened to “create the next Columbine shooting” if he was dismissed from his position. On Sunday, authorities took 23-year-old Mario Vernal into custody after he reportedly made threats towards a camper at Camp Cho Yo in Livingston. Witnesses informed the police about his statements. According […]
You Need to Step Down, Costing $400B a Year

Sen. Bernie Moreno Critiques Federal Reserve Chairman Senator Bernie Moreno (R-OH) expressed his frustration with Senate Chairman Jerome Powell, who has criticized President Trump’s trade policies. Moreno accused the government of neglecting the issue of inflation, which he attributes to Democratic leadership, along with a staggering $400 billion annual expenditure. In a post on X, […]
Mediator suggests $20 million settlement in Trump’s case against Paramount and CBS

Trump’s Lawsuit Settlement Proposal with Paramount and CBS News In a significant development regarding President Donald Trump’s legal battle against Paramount and CBS News, a mediator has suggested a $20 million settlement to resolve the ongoing lawsuit. This information comes from sources reported on Wednesday. According to reports, Trump’s legal team was presented with a […]
Zohran Mamdani’s unexpected win stemmed from liberal NYC areas and a much wider group of voters than anticipated for a socialist.

Mamdani’s Surprising Win in Democratic Mayoral Primary Zoran Mamdani’s unexpected triumph in the Democratic mayoral primary was largely fueled by support from Brooklyn’s Granola area, although socialists have made significant inroads among Black and Hispanic voters as well. The 33-year-old lawmaker from Queens made a strong showing in early results, especially within the liberal stronghold […]
Leader of Tren de Aragua gang added to FBI’s Ten Most Wanted list

Tren de Aragua Leader Added to FBI’s Most Wanted List The leader of the Tren de Aragua gang, Giovanni Vicente Mosquera Serrano, has recently made it onto the FBI’s list of the ten most wanted fugitives, marking a notable moment for this notorious group. At 37 years old, Serrano aims to coordinate drug trafficking and […]
Sleep specialists talk about the advantages and possible health dangers of mouth taping.

Mouth taping is making a comeback as a bedtime trend, similar to its previous surge a few years back. The main idea? To tape your mouth shut while you sleep, encouraging nasal breathing. Some experts claim this practice may offer health benefits, though there are others who caution against potential risks and unexpected consequences. The […]
Kevin Costner refutes claims about a stuntwoman’s ‘unscripted rape scene’

Kevin Costner Faces Lawsuit from Stunt Woman Over Alleged Incident Kevin Costner is currently involved in a legal battle with stuntwoman Devin Labella. She has accused him of staging a “violent, unscripted rape scene” on the set of “Horizon: American Saga – Chapter 2” without her consent. Costner’s attorney, Marty Singer, responded to Labella’s claims, […]
Trump urges the dismissal of a CNN reporter due to a report on Iran’s nuclear damage

President Trump expressed his desire for CNN correspondent Natasha Bertrand to be fired on Wednesday after commenting on a U.S. intelligence report. This report suggested that a recent strike on Iran’s nuclear sites had delayed Tehran’s nuclear program for several months. Trump took to his social media platform, stating, “Natasha Bertrand should be fired from […]
Maine lawmaker reinstated after being censured for comments about a trans athlete

Maine Representative Laurel Libby Regains Speech Rights Maine Representative Laurel Libby had her speech rights restored by fellow state lawmakers on Wednesday, following criticism from a social media post that identified a transgender athlete. The Supreme Court had previously restored Libby’s voting rights on May 20 after she filed a lawsuit regarding the accusations against […]
Tomb ‘curse’ of ancient mummy leads to new cancer treatment medication
Toxic Fungus from Ancient Tombs Shows Potential for Cancer Treatment Research suggests that a toxic fungus, once believed responsible for fatal lung infections among tomb explorers, could lead to effective new cancer therapies. Shortly after the 1922 discovery of King Tutankhamun’s tomb, the earl who financed the excavation died, sparking rumors that the mummy had […]